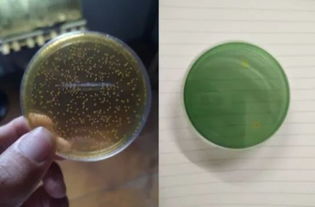
蝦蟹養(yǎng)殖業(yè)的革新曙光 南山生物科技金甸系列生物制品重磅發(fā)布

自然科學(xué)與生物制品 探尋文靜齋醫(yī)學(xué)書店與孔夫子舊書網(wǎng)的獨特價值

自然科學(xué)作為人類探索世界本質(zhì)的基石,涵蓋了生物學(xué)、醫(yī)學(xué)等眾多領(lǐng)域,其中生物制品作為現(xiàn)代醫(yī)學(xué)與生物技術(shù)的重要組成部分,在疾病預(yù)防、診斷和治療中發(fā)揮著關(guān)鍵作用。生物制品包括疫苗、血液制品、基因工程藥物等,它們的研發(fā)和應(yīng)用依賴于深厚的理論基礎(chǔ)和持續(xù)的創(chuàng)新實踐。在這一過程中,知識的獲取與傳播至關(guān)重要,而文靜齋醫(yī)學(xué)書店與孔夫子舊書網(wǎng)則成為連接過去與未來的橋梁。
文靜齋醫(yī)學(xué)書店作為一家專注于醫(yī)學(xué)領(lǐng)域的實體書店,長期致力于收集和推廣自然科學(xué)相關(guān)的經(jīng)典著作與前沿文獻。從基礎(chǔ)生物學(xué)教材到生物制品的專業(yè)指南,這里不僅提供最新的研究成果,還珍藏了許多絕版書籍,為醫(yī)學(xué)工作者、學(xué)生和研究者提供了寶貴的資源。其特色在于對自然科學(xué)知識的系統(tǒng)整理,幫助讀者深入理解生物制品的原理與應(yīng)用,例如在疫苗開發(fā)中涉及的免疫學(xué)理論,或生物制藥中的質(zhì)量控制標(biāo)準(zhǔn)。
與此同時,孔夫子舊書網(wǎng)作為國內(nèi)領(lǐng)先的舊書交易平臺,為自然科學(xué)愛好者開辟了另一條知識獲取途徑。在這個數(shù)字化的時代,舊書網(wǎng)不僅讓稀缺的醫(yī)學(xué)文獻得以流通,還促進了生物制品歷史資料的保存與分享。用戶可以在平臺上找到上世紀(jì)出版的生物技術(shù)手冊、早期疫苗研究論文,甚至是文靜齋書店的舊藏書籍。這些資源不僅具有收藏價值,更讓新一代研究者得以追溯生物制品的發(fā)展歷程,從中汲取靈感。例如,通過舊書網(wǎng)獲取的早期生物制品實驗記錄,可能為現(xiàn)代藥物研發(fā)提供新的視角。
文靜齋醫(yī)學(xué)書店與孔夫子舊書網(wǎng)在自然科學(xué)領(lǐng)域,特別是生物制品方面,扮演了互補的角色:前者通過實體服務(wù)推動知識的深度傳播,后者則利用網(wǎng)絡(luò)平臺實現(xiàn)資源的廣泛共享。它們共同構(gòu)建了一個多維的學(xué)習(xí)環(huán)境,助力生物制品從實驗室到臨床的轉(zhuǎn)化。未來,隨著生物技術(shù)的不斷進步,這些知識載體將繼續(xù)為自然科學(xué)的發(fā)展注入活力,推動人類健康事業(yè)的持續(xù)創(chuàng)新。
如若轉(zhuǎn)載,請注明出處:http://m.laozj.cn/product/2.html
更新時間:2026-04-14 06:38:51